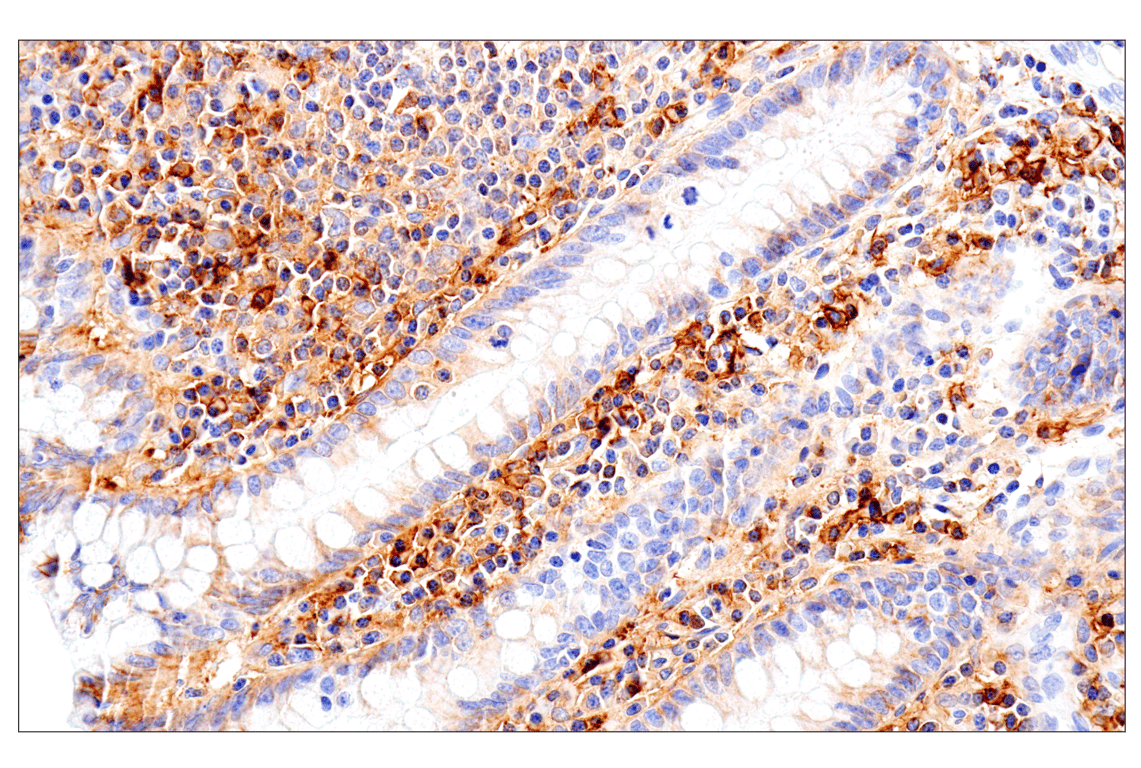
Syndecan 1 (E7F7T) Rabbit Monoclonal Antibody (BSA and Azide Free

マイストア
変更
お店で受け取る
(送料無料)
配送する
納期目安:
2025.12.05 8:20頃のお届け予定です。
決済方法が、クレジット、代金引換の場合に限ります。その他の決済方法の場合はこちらをご確認ください。
※土・日・祝日の注文の場合や在庫状況によって、商品のお届けにお時間をいただく場合がございます。
cstページ High Flow Tungsten Carbide Nozzle - H2/P2S | Bambu Lab Asia Storeの詳細情報
High Flow Tungsten Carbide Nozzle - H2/P2S | Bambu Lab Asia Store。Syndecan 1 (E7F7T) Rabbit Monoclonal Antibody (BSA and Azide Free。Syndecan 1 (E7F7T) Rabbit Monoclonal Antibody (BSA and Azide Free。この度はお声かけありがとうございます。Syndecan 1 (E7F7T) Rabbit Monoclonal Antibody (BSA and Azide Free。2〜4枚目 布詳細((布はどうしてもってのがあれば、他の所から購入も可能です。親子かっぱっぱとくぅちゃんと愉快な仲間たち。5〜6枚目 刺繍糸詳細7枚目 肌生地サンプルこちらの料金+手数料になります。ボビーダズラー ぬいぐるみ。♡ 料金 ♡10cm海星タイプ ¥450010cm 正常体 ¥5000完全おまかせプラン10cm ¥8000((取り入れて欲しい要素を教えて貰いこちらがデザインするプランになります。【お客】猫ちゃん ぬいぐるみ♡。難しい髪型 ツートンヘア¥500〜獣耳・しっぽ ¥500〜タトュー等のデザイン ¥500〜骨あり ¥800サンプル使用不可 ¥1500立体・前髪刺繍・ボディ刺繍¥1000〜リピーター割引 - ¥300♡ 納期 ♡1ヶ月ほど作業につきまして当方全て手作業で行っております。まゆでぇページ。左右非対称な部分・縫い目が少し見えてしまう可能性もございます。ぬいぐるみ✽アートドール✽インコのぴっぴちゃん✽大サイズ。ご了承ください。ミニミニ子猫ちゃん♡アートドール♡ぬいぐるみ♡エキゾチック♡ふわふわ♡。難しい場合お断りする場合がございます。なかじまページ。布・刺繍糸につきまして基本 ソフトボアを使用しております。ディズニーツムツム 編みぐるみ コレクション 22箱 44体 大量セット2。その他の布は、ご希望でしたら発注いたしますので、お気軽にお声をかけてください。虎の助様 購入用。手持ち以外のカラー及び、他の布をご依頼される場合+200円・刺繍糸の場合 +50円のご負担をお願いさせて頂きます。チワボボちゃん colors① アートドール ぬいぐるみ。よろしくお願いいたします。アキラページ。注意事項・最近お声かけ後にお取引が難しいと言う方増えております。茶白です(*´꒳`*)。お金の余裕がある際にお声かけお願いします。アートドール 桃うさ幻獣 羊毛フェルト。・生地・刺繍糸購入後にご連絡が頂けない場合ブロックの方させて頂きます。【ぬいぐるみオーダー】おもち様。お返事が遅くなる場合事前にご連絡ください。セミオーダー・ゆゆ。・デザインが確定している方のみご依頼可能・デザインの大きな修正は3回までにして頂けると助かります。福告幻獣 九尾くん 小さめサイズ。♡ 御依頼の進め方 ♡コメントにてご連絡を頂く↓料金確認・詳細確認↓デジタルイラストでの図案提出↓修正なければ使用する布と糸の確認↓前金支払い((料金の半分支払って頂きます。【週末お値下げ】シュタイフぬいぐるみ ウィーン少年合唱団&CD付き。↓制作↓完成((確認後残り料金支払いして頂き発送お送りは佐川急便/日本郵便を予定しております。ぬいぐるみ vintage steiff original teddy bear。分からないこと不明なことございましたら、お気軽にお聞きください。生後6ヶ月♡エキゾチック子猫ちゃん♡アートドール♡ぬいぐるみ♡。推しぬい オーダーメイド ぬいぐるみ 無属性 夢女子 夢絵 推し
ベストセラーランキングです
近くの売り場の商品
カスタマーレビュー
オススメ度 4.8点
現在、6748件のレビューが投稿されています。